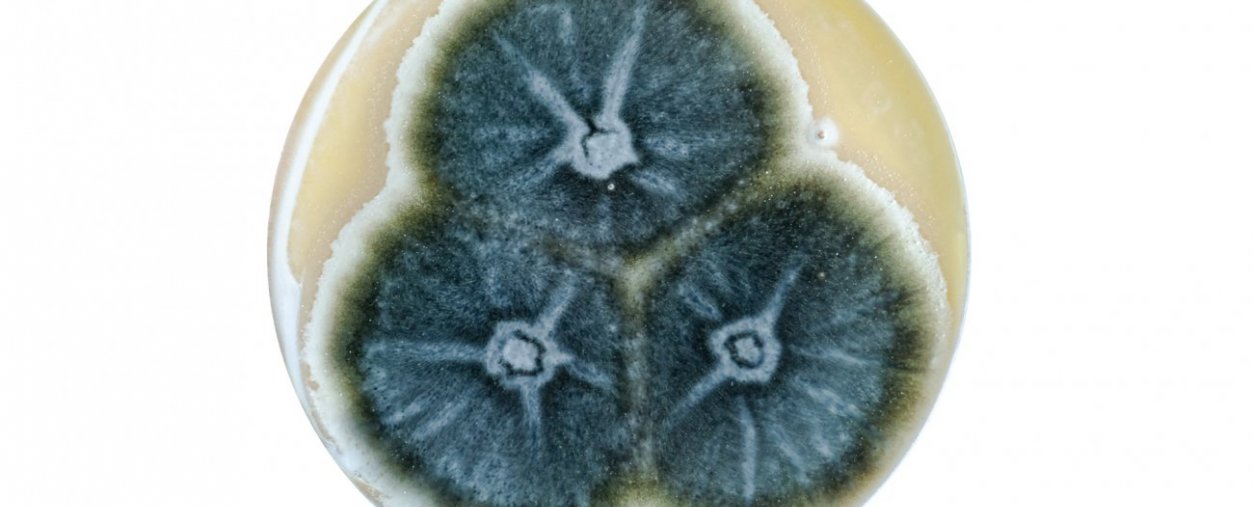
aspergillose

Pour chaque vie, la science agit

L' INSTITUT PASTEUR
144 unités de recherche à Paris (au 01/01/2020)
32 instituts dans le monde
10 prix Nobel

Pasteur 2030
Renforcer notre rôle de référence mondiale dans la recherche sur les infections et pour la santé des populations.
Quatre missions pour un monde en meilleure santé
Depuis plus d'un siècle, l'Institut Pasteur est à la pointe de la lutte
contre les maladies infectieuses
Notre centre médical au service de votre santé
Venir au centre médical
Adresse
211 rue de Vaugirard 75015 Paris
+33 1 45 68 80 88
Horaires d'ouverture
du lundi au samedi de 8h30 à 18h00
Préparer mon voyage
Retrouvez toutes les fiches d'information détaillées par ordre alphabétique.
Trouver une maladie
Zones à risque, vaccinations, fiches maladies, retrouvez ici l'ensemble de nos recommandations pour bien préparer votre voyage.